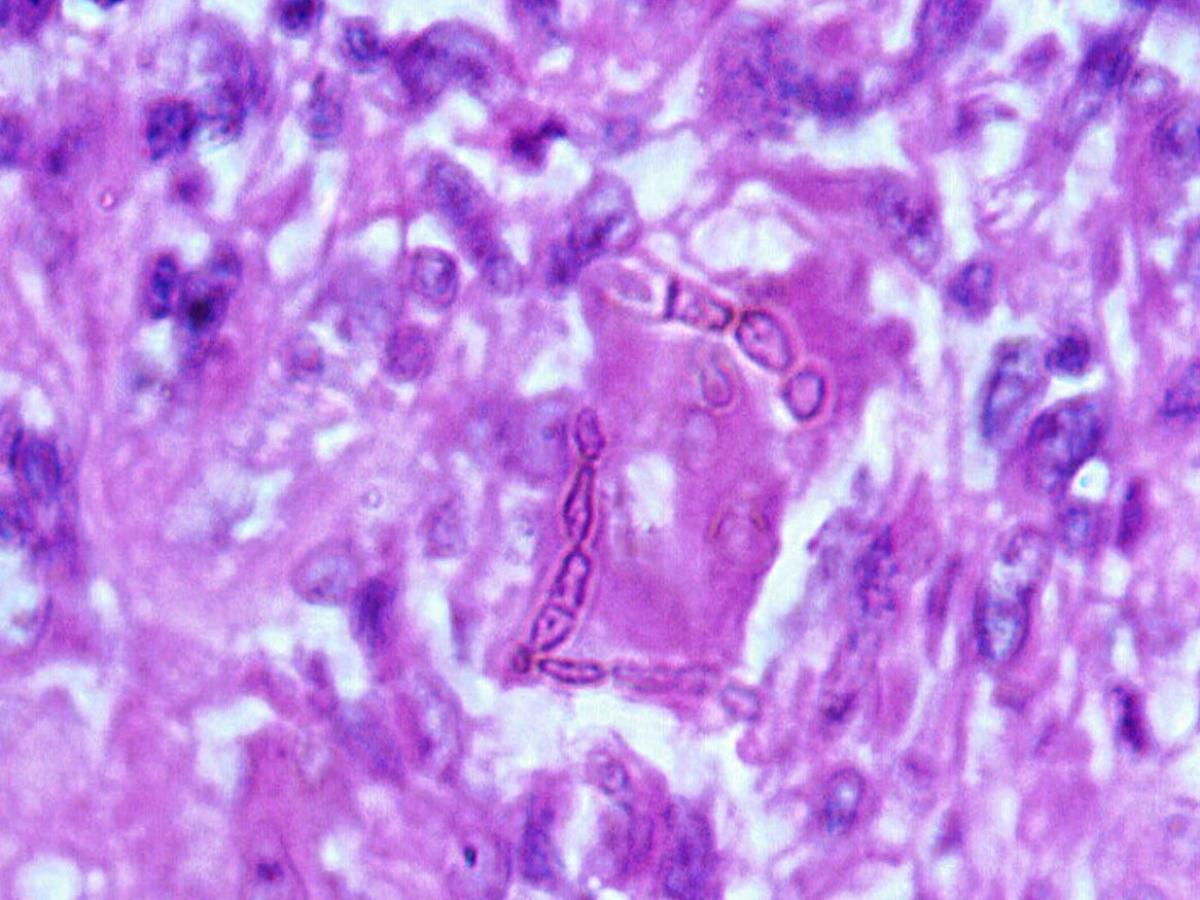
Histopathology
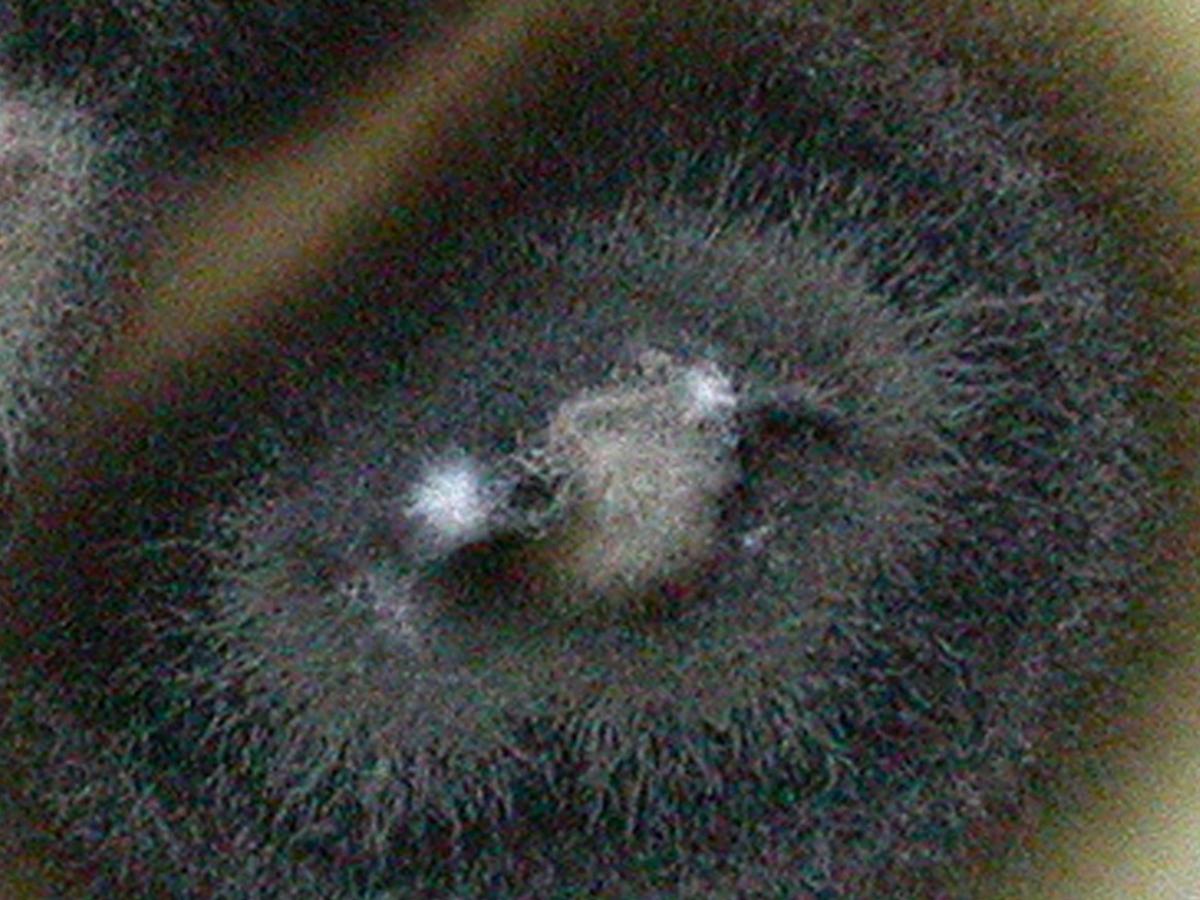
Culture

Status message
Correct! Excellent, you have really done well. Please find additional information below.
Unknown 64 = Cladophialophora bantiana
Histopathology: H&E stained section showing characteristic, brown-pigmented, septate hyphal elements. The hyphae may be short to elongate, distorted or swollen, regularly shaped, or any combination of the above.
Note: direct microscopy of tissue is necessary to differentiate between chromoblastomycosis and phaeohyphomycosis where the tissue morphology of the causative organism is mycelial.
Culture: Colonies are moderately fast growing, olivaceous-grey, suede-like to floccose and grow at temperatures up to 42-43C.
Microscopy: Conidia are formed in long, sparsely branched, flexuous, acropetal chains from undifferentiated conidiophores. Conidia are one-celled (very occasionally two-celled), pale brown, smooth-walled, ellipsoid to oblong-ellipsoid and are 2-3 x 4-7um in size.

Comment: Cladophialophora bantiana may be distinguished from Cladosporium species by the absence of conidia with distinctly pigmented hila, the absence of characteristic shield cells and by growth at 42C (compared with Cladophialophora carrionii which has a maximum growth temperature of 35-36C). RG-3 organism.
Cladophialophora bantiana has been isolated from soil and is a recognized agent of cerebral phaeohyphomycosis. The fungus is neurotropic and may cause brain abscess in both normal and immunosuppressed patients.
About Cladophialophora Back to virtual assessment